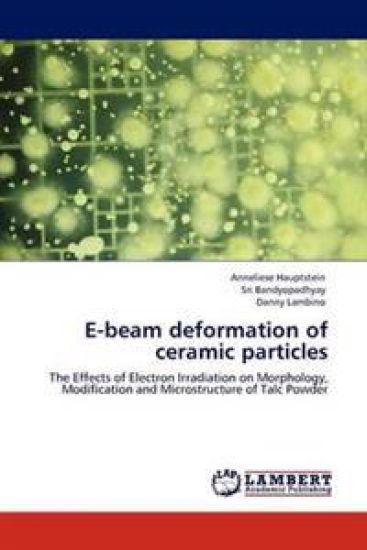
E-beam deformation of ceramic particles

Kirjahaku
Etsi kirjoja tekijän nimen, kirjan nimen tai ISBN:n perusteella.
1000 tulosta hakusanalla Beam Alex


Cone Beam Computed Tomography in Implantology and Dentistry
V N V Madhav
LAP Lambert Academic Publishing
2012
pokkari

Ion beam analysis of wide bandgap semiconductor heterostructures
Andrés Redondo-Cubero
Lap Lambert Academic Publishing
2012
nidottu

Cone Beam Computed Tomography
Tarun Kumar; Gagan Puri; Sanjeev Laller
Lap Lambert Academic Publishing
2014
nidottu

Composite Beam to Cfst Column Connection Beahviour
Hajivandi Mohammad Amin
LAP Lambert Academic Publishing
2013
pokkari

Ion Beam Induced Nanoscale Ripples on Si, Tio2 and Ti Surfaces
Fravventura Maria C
LAP Lambert Academic Publishing
2013
pokkari

Cone Beam Computed Tomography (CBCT)- An Imaging Atlas
Suresh Ludhwani; Anjani Chaudhary; Bhavin Dudhia
Lap Lambert Academic Publishing
2014
nidottu


Electron Beam Induced Mass Loss of Sensitive Materials
LAP Lambert Academic Publishing
2014
pokkari

Cone beam computed tomography
Apoorva Gupta; Parvathi Devi M.
Lap Lambert Academic Publishing
2017
nidottu

Electron Beam Irradiation on Copper(II) Schiff Base Complex
S. Theodore David Manickam; P. R. Sagunthala Devi
Lap Lambert Academic Publishing
2016
nidottu

Electron Beam Irradiated LLDPE & Silicone Rubber Blends
Radhashyam Giri; Kinsuk Naskar; Golok Bihari Nando
Lap Lambert Academic Publishing
2016
nidottu

Laser Beam Propagation in the Atmosphere
Springer-Verlag Berlin and Heidelberg GmbH Co. K
2014
nidottu
With contributions by numerous experts

Ion Beam Therapy
Springer-Verlag Berlin and Heidelberg GmbH Co. K
2016
nidottu
The book provides a detailed, up-to-date account of the basics, the technology, and the clinical use of ion beams for radiation therapy. Theoretical background, technical components, and patient treatment schemes are delineated by the leading experts that helped to develop this field from a research niche to its current highly sophisticated and powerful clinical treatment level used to the benefit of cancer patients worldwide. Rather than being a side-by-side collection of articles, this book consists of related chapters. It is a common achievement by 76 experts from around the world. Their expertise reflects the diversity of the field with radiation therapy, medical and accelerator physics, radiobiology, computer science, engineering, and health economics. The book addresses a similarly broad audience ranging from professionals that need to know more about this novel treatment modality or consider to enter the field of ion beam therapy as a researcher. However, it is also written for the interested public and for patients who might want to learn about this treatment option.

Laser beam melting of immiscible FeMn-AgX for adapted bioresorbability
Jan Tobias Krüger
Books on Demand
2023
pokkari


Wie soll man nur zu seiner Mitte finden, wenn der Nachbar jeden Samstag früh seinen 6,5 PS Monstermäher anwirft? Was haben die Vorlieben des Homo erectus mit dem Seelenfrieden des modernen Menschen zu tun? Was tun, wenn sich partout kein Joint Venture mit dem inneren Schweinehund knüpfen lässt? Wie aus dem Teufelskreis des Kann-Meinen-Bürokollegen-Nicht-Leiden, Kann-Mich-Nicht-Leiden, heraus kommen? Das Buch geht diesen und anderen Fragen nach. Daneben offenbart es aber auch eine faszinierende Methode, diesen täglichen Fallen zu begegnen: Selbsthypnose. Der Leser lernt anhand eines, durch die amüsant beschriebene Art, kurzweiligen Übungsprogramms, das imstande ist, einen neuen, unkonventionellen Zugang zu sich selbst zu öffnen.

Cryogenic Beam Loss Monitoring for the LHC
Christoph Kurfürst
Sudwestdeutscher Verlag Fur Hochschulschriften AG
2015
pokkari

Planar beam-forming antenna array for 60-GHz broadband communication
Johannes Akkermans
Lap Lambert Academic Publishing
2010
nidottu
E-beam deformation of ceramic particles
Anneliese Hauptstein; Sri Bandyopadhyay; Danny Lambino
LAP Lambert Academic Publishing
2011
pokkari
